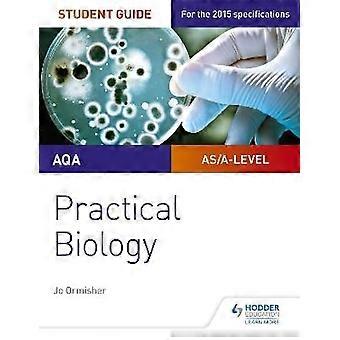

Education
Shop the best prices on 76,354 great value education. Shopping for education is easy with Fruugo, with SALE discounts, offers and savings on ClimateStar. Buy education online safely with Fruugo, with secure payment and fast shipping to United States.
Filters
2,177 - 2,208 of 76,354